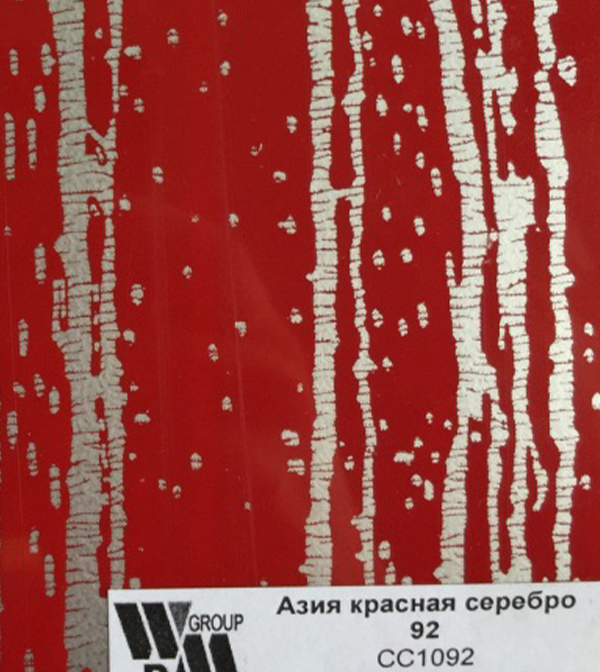

+7(499)348-12-97
c 9:00 до 20:00
zakaz@faslux.ru
Просчеты, заказы
Фантазийные пленки ПВХ

ОСТАВЬТЕ ЗАЯВКУ НА ПРОСЧЕТ:
Если ваш заказ больше 8 м2, вы можете получить доступ к оптовым ценам.